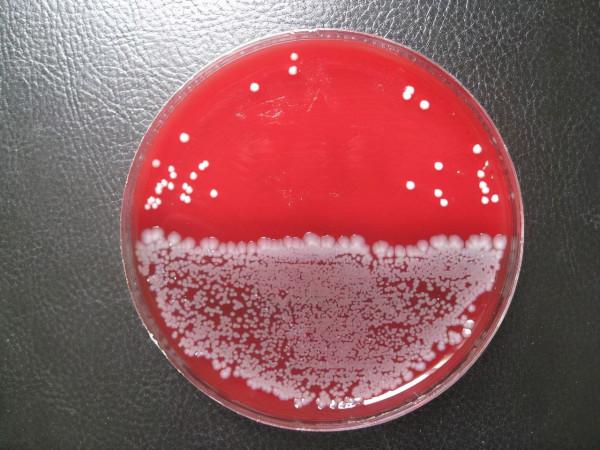
天生的“酒桶”!男子腸道自動釀酒,不喝酒也常醉倒,究竟為何? 天生的“酒桶”!男子腸道自動釀酒,不喝酒也常醉倒,究竟為何?

生活中有很多事會讓人尷尬,比如拉肚子,一趟又一趟地跑廁所;又比如放屁,有的人因為腸胃的關係,吃過多的澱粉之類的食物就會狂放屁。這些都較為常見,但是人的腸胃卻會發生很多難以解釋的現象。
據報道,美國美國賓夕法尼亞州匹茲堡40歲的牧師亞當·斯頓普常被人們誤認為是一名酒鬼,她妻子也懷疑他表面一套背地裡又是一套,認為他在某處偷喝酒搞得渾身酒氣、醉醺醺的。他自己去醫院進行過檢查,結果是沒有什麼腸道的疾病。他的妻子被這個事搞得很苦惱,因為他曾在演講時突然語無倫次。所以他的說法確實容易讓人產生懷疑,妻子還曾為了提防他喝酒而一整天陪著他。
結果發現,丈夫確實一整天沒有喝酒,但是最後卻醉了,這時女子還懷疑,覺得丈夫是裝的。但是在進行了酒精檢測之後,她的丈夫確實喝醉了,酒精濃度超標。這就讓人大吃一驚,這種憑空喝醉的情況真的存在嗎?經常醉醺醺的酒鬼,不是在喝酒就是去買酒的路上,自己的丈夫並沒有喝酒卻醉醺醺的。驚嚇之餘二人又去醫院進行檢查。
而這一次確定了男子的問題,醫生說該男子患上了一種名為“自動釀酒綜合症”的罕見疾病,而且這種疾病早就被記錄在案。2013年,在美國德克薩斯州帕諾拉縣的一名61歲的男子在家裡無緣無故地暈倒,家人自然是慌忙把他送去醫院,醫生抽血檢查後卻發現該男子血液中的酒精濃度已經達到了酒駕標準的5倍,但該男子否認曾飲酒;在英國也有相關案例記載。
據症狀表現出的特徵,一些學者認為這種疾病是由於腸道菌群的緣故。我們人類掌握了食物的發酵,釀酒就是用酒麴(含有酵母菌的團塊)發酵糧食產生的。在密閉的環境中,酵母菌可以進行無氧呼吸,將澱粉轉化為酒精。化學過程非常複雜,不過可以根據物質的最終走向而用C₆H₁₂O₆(葡萄糖)→2C₂H₅OH(酒精)+2CO₂(二氧化碳)+ATP(能量)這個化學式表示。
在人類中確實有因為酵母菌導致的疾患,有些人常有腹痛腹瀉等毛病,檢查後會發現糞便酵母菌。糞便酵母菌是常見的真菌,可隨環境汙染而進入腸道,也可見於服用酵母片之後。 多見於夏季已發酵的糞便中。本檢查是大便常規中的一個專案,大便中檢出酵母菌無臨床意義。糞便酵母菌包括普通酵母菌,人體酵母菌,假絲酵母菌等,普通酵母菌就可產生酒精。
如果腸道內有較多的酵母菌或者白色念珠菌,它們就可能消化食物中的澱粉進而產生酒精,而腸道又是水等營養素吸收的重要場所,酒精會從高濃度向低濃度流動,所以腸道中產生的酒精就被自然而然地吸收了,導致血液中存在較多的酒精,可能達到大於80毫克/分升的程度。 醫生給出的治療方式是不能吃澱粉類的食物,只能吃肉蛋奶等食物,以減少酒精的產生。
不過這樣飲食依然會讓人難受,還會出現噁心、腹瀉和胃痙攣等症狀,想要根治的話可能需要腸道灌洗,然後再注入菌株製劑以改變腸道菌群的型別。由於這種疾病較少,具體的原因未完全解析,而且也有學者認為這樣的說法是偽科學。不過隨著多個國家有這種案例的記載,也漸漸被一些學者所接受,又被稱為腸道發酵綜合徵,但是還是缺乏研究資料,具體原因還不能下定論。
由於腸道菌群導致的疾病很多,菌群和人體算是共生的關係,它們隨著食物進入腸道,在腸道內可以協助人消化部分食物。一般情況下,各種菌群加上人體免疫的作用,菌群協調平衡,不同的菌株之間又存在著生存競爭,進而在腸道中和諧共存。可是藥物、偏好某種食物等因素可能導致某一種或者某類菌群佔優勢地位,那麼就可能引發疾病。